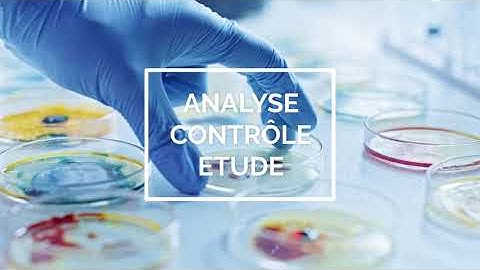
Laboratoires Bio Goujard - Nos domaines d

⬇ DOWNLOAD NOW
Kalau muncul iklan pop-up, tutup lalu klik tombol kembali
Download lagu Elise Goujard: Volumes of odd strata of quadratic differentials secara gratis hanya untuk keperluan promosi. Dukung artis favorit kamu dengan membeli musik original di iTunes atau platform resmi lainnya.
 Elise Goujard (Universit´e de Bordeaux) 26.01.2023
Elise Goujard (Universit´e de Bordeaux) 26.01.2023
 Elise Goujard "Variations on meanders" (after a joint work with V.Delecroix, P.Zograf and A.Zorich)
Elise Goujard "Variations on meanders" (after a joint work with V.Delecroix, P.Zograf and A.Zorich)
 Élise Goujard: Flat surfaces and combinatorics
Élise Goujard: Flat surfaces and combinatorics
Laboratoires Bio Goujard - Nos domaines d'activité
Laboratoires Bio Goujard - Nos domaines d'activité
 Jeu d'enfants
Jeu d'enfants
 1.1. Even/Odd Rules
1.1. Even/Odd Rules
 Measured laminations, earthquakes, and horocycles (Aaron Calderon, NCNGT 2/2)
Measured laminations, earthquakes, and horocycles (Aaron Calderon, NCNGT 2/2)
 Portrait Pierre Goujard
Portrait Pierre Goujard